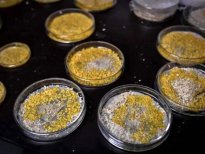

2 dakikada iyileşen canlının 720 cinsel organı var, ama beyni yok!
Paris Hayvanat Bahçesi'nde sergilenen ilk bitki olan Blom yani 'Damla' tek hücreli ve doğanın gizemlerinden biri olarak görülüyor. Hayvanat bahçesinin bu tuhaf misafiri 'beyni' olmamasına rağmen 'öğrenme yeteneği' ile büyülüyor. Dahası kendini 2 dakikada iyileştirebiliyor.
Yosunu andıran bu tek hücreli canlı mantar gibi görünüyor ama bir hayvan gibi hareket ediyor ve tam 720 cinsel organa sahip. Ne olduğu tam olarak çözülemeyen bu canlıya 'Blob' adı verildi. İşte 2 dakikada kendini iyileştirebilen dün
03 Haziran 2020 Çarşamba 16:45
1 / 11